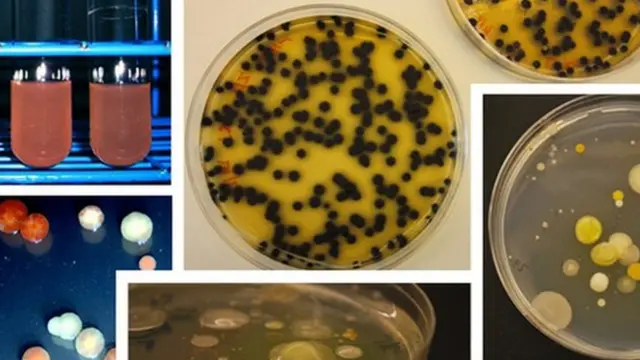
čaški petri

Nauka i tehnologija: Naučnici našli način da sačuvaju informacije direktno na DNK

Autor fotografije, IMDB
- Autor, Nikolaj Voronjin
- Funkcija, Dopisnik iz oblasti nauke
„Džiu-džicu? Naučićete me džiu-džicu?!", junak filma „Matriks", Kijanu Rivs gleda u operatera sa nevericom.
Ovaj mu samo namigne kao odgovor, pređe prstima preko dugmića i lice Odabranog se iskrivi u grimasu nepodnošljivog bola.
Ipak napad je kratko trajao i već nakon par sekundi jedva je podigao glavu sa stolice i sa uzbuđenjem i kroz izdah rekao: „Ja znam kung fu!".
Čuvena scena iz filma „Matriks" možda i nije tako daleko od realnosti, kako nam se to svima činilo pre nekih 20 godina.
Američki naučnici sa Univerziteta Kolumbija iz Njujorka razvili su tehnologiju koja omogućava kopiranje informacija sa bilo kog digitalnog medija direktno na DNK, praktično pretvarajući ćelije živih organizama u minijaturne uređaje za beleženje i čuvanje podataka.
Naravno, teško da će moći da se uče borilačke veštine na taj način u bliskoj budućnosti ali nova tehnologija pruža niz drugih mogućih primena.
Na primer, ako učitate kompjuterski kod bilo koje ešerihije koli u DNK to se nikako neće odraziti na njenu sposobnost razmnožavanja.
Već zapravo to znači, da takvi „oživljeni programi" mogu beskonačno da štampaju svoje kopije u Petrijevoj čaši na najprirodniji način, neprekidno ažurirajući šifrovani kod koji se nalazi u njima.
Drugim rečima, potrebne informacije mogu da se čuvaju i hiljadama godina u neizmenjenoj formi.
Za sada je nova tehnologija, daleko inferiornija u odnosu na druge, nama poznate metode čuvanja informacija, kako po brzini, tako i po zapremini uređaja za snimanje.
Ipak, prema rečima naučnika, ona je pouzdana u pogledu zaštite od grešaka, jer je sistem beleženja genetskih informacija, bez ikakvog preterivanja, star koliko i sam život.
Kako to funkcioniše?
Sama tehnologija sastavljanja DNK nije nova.
Postoje samo četiri azotne baze koje čine genetski kod.
U laboratorijskim uslovima mogu da se sastave u lanac, nižući ih jednu za drugom, kao perle, po proizvoljnom redosledu.
To se radi pomoću tehnologije CRISPR-Cas9, poznatije kao „genetske makaze".
Razvijen je pre osam godina, a prošle godine je nagrađena Nobelovom nagradom za hemiju.
Međutim, sastavljanje genetskog koda na molekularnom nivou je mukotrpan posao: potrebno je mnogo vremena i posebna oprema.
U svakom slučaju, tako je bilo doskora, dok grupa naučnika sa Univerziteta Kolumbija nije uspela da automatizuje ovaj proces.

Autor fotografije, Getty Images
„Uspeli smo da naučimo ćelije da razgovaraju sa računarom putem elektronskih signala i na taj način preuzmemo informaciju sa bilo kog elektronskog uređaja", kaže za BBC glavni autor studije, profesor sistemske biologije Haris Vang.
Eksperimenti su se odvijali u njegovoj laboratoriji koristeći bakteriju Ešerihiju koli.
Ova bakterija je toliko dobro proučena da mikrobiolozi često koriste njene ćelije u eksperimentima kao zamorčiće.
Međutim, naglašava profesor, CRISPR-Cas9 je takođe odličan za korekciju ljudskog genoma.
Što znači, možemo da se nadamo, da će u budućnosti informacije moći da se kopiraju sa računara direktno u ćelije ljudi.
Gotovo kao u Matriksu ili u filmu Džoni Mnemonik, sa istim onim Kijanuom Rivsom u glavnoj ulozi.

Autor fotografije, Columbia TriStar
„Prevodimo binarni kod računarskog programa (skup nula i jedinica) u električne impulse koje šaljemo u ćeliju", objašnjava pronalazač.
Na njenoj površini postoje receptori koji usvajaju ove signale i već ih prevode na jezik DNK, automatski gradeći željenu sekvencu genoma."
Kao rezultat toga, dodatni fragment se dodaje glavnom lancu DNK, tj. specifična „informaciona prikolica".
Za razliku od digitalnih računarskih informacija, on je skup slova genetskog koda (odnosno analogna šifra) i zbog toga naučnik upoređuje ovaj segment sa magnetnom trakom.
Utkana u DNK bakterije, informacija postaje deo njenog genoma i automatski se kopira sa svakom ćelijskom deobom.
„A to znači da ćemo kasnije, pošto pročitamo ovu sekvencu, moći da obnovimo, ponovo stvorimo informacije uskladištene u populaciji ćelija", kaže profesor.

Autor fotografije, Columbia University
Kako zapisati dva bajta?
U početku eksperiment se izvodio kako bi se automatizovao složeni proces sastavljanja DNK, i kako bi se on učinio dostupnijim, da ne zahteva posebno znanje i opremu.
Međutim, prema rečima profesora sa Univerziteta centralne Floride u Orlandu, Dmitrija Kolpaščikova, korišćenje dugih fragmenata DNK za beleženje informacija prilično je neefikasno.
Opšteprihvaćena metoda, kad se prilikom sastavljanja u laboratoriji, svaka karika polimernog lanca DNK kodira jedan ili čak nekoliko bitova informacija, mnogo je efikasnija.
„Da bi se zabeležio jedan bit informacija, ćeliji su slati električni signali tokom 14 časova, preispituje se on.
Kako bi se takvoj tehnologiji pronašla neka praktična primena potrebno je da se proces znatno ubrza.
Međutim, nema očiglednih načina da skrate ovo vreme: da bi se učitao jedan bit potrebno je sat vremena, a možda i nekoliko sati.
Tokom sprovođenja eksperimenta koji je trajao 42 sata naučnicima je pošlo za rukom da zabeleže na DNK samo 3 bita informacija.
Ali da bi ove informacije mogle da se uzmu u obzir u budućnosti, potrebno je da se sprovede potpuno dekodiranje DNK bakterije, čto uz trenutni nivo tehnologije nije teško, već zahteva puno vremena i novca.
Sekvenciranje genoma je skupo.
Profesor Vang kaže da su u laboratoriji namerno usporili proces, a obim učitanih informacija u DNK formatu u teoriji može biti i veći nego što dozvoljavaju savremene tehnologije.
Da ne spominjemo to da sa aspekta brzine teško da je izgradnja ćelija inferiorna u odnosu na brzinu digitalnog zapisa.
Autor fotografije, Columbia University
„Vreme rada na računaru meri se u milisekundama, ali neki ćelijski enzimi mogu da rade jednako brzo", kaže on.
„Možda ćemo u budućnosti uspeti da razvijemo neku vrstu unutarćelijskih mehanizama koji će omogućiti da se porces u velikoj meri ubrza.
„U teoriji ništa ne sprečava stvaranje ćelije koja će u potpunosti kopirati svoj genom za samo nekoliko minuta."
Međutim, prema rečima profesora Kolpaščikova, čak i u ovom slučaju, metoda koju su predložili Amerikanci, teško da će biti efikasnija, od metoda beleženja informacija koje danas postoje.
Tako da čak nema mnogo smisla razvijati novu tehnologiju, ako se, naravno, radi samo o načinu čuvanja podataka.
Međutim, možda će ona dobiti i drugu primenu.
Vanvremenski
Veštački sastavljeni lanci genetskog koda koriste se u razne svrhe.
Na primer, u laboratoriji na čijem je čelu Kolpaščikov, od takozvane kompjuterizovane DNK sklapaju se nanoroboti za lečenje bolesti kancera, gripa, kao i za izvođenje eksperimenata u oblasti genetskog inženjeringa.
Ako se uspe da se postupak sklapanja automatizuje i ubrza, onda potražnja za tehnologijom koju su razvili Amerikanci može biti velika.
Zapravo, na ovaj ili onaj način, ona omogućava uspostavljanje direktnog kanala za prenos podataka između računara na koje smo navikli i živih ćelija.
I iako ovaj kanal do sada nije najbrži i najpouzdaniji, prema rečima profesora Vanga, imamo još jednu veoma važnu prednost.
„U DNK informacije su zabeležene u trodimenzionalnom analognom obliku, a to je najstabilniji oblik. U tom obliku podaci mogu da se čuvaju stotinama hiljada, pa čak i milionima godina", uverava on.
Pa ni danas ponekad nije tako jednostavno da se pronađe način za čitanje podataka sa laserskog diska ili magnetne trake, a da ne govorimo o karticama sa perforacijama.
Svi ovi nosači informacija su kratkog veka i sve tehnologije brzo zastarevaju, podseća profesor.
Ali genetski kod ne mari za ovaj problem.

Autor fotografije, Science Photo Library
„Znamo da ćemo za 50 hiljada godina moći da dešifrujemo DNK na potpuno isti način kao i danas, siguran je Haris Vang.
„Koji to još oblik zapisa ima takvu sposobnost?".
Kolpaščikov ne osporava ove tvrnje:
„U stvari [zbog razmnožavanja] vrši se biološka podrška za održivost bakterija, bez obzira što tu mogu da se akumuliraju greške. U potpunosti se slažem: ovo je dobar argument."
Što se tiče mogućih grešaka programeri su optimistični.
Prema njihovim rečima, niko neće u spoljnu sredinu puštati bakterije sa „informacionom prikolicom", gde moraju da se bore za opstanak, kako im prirodna selekcija ne bi bila pretnja.
„Zanimljiv razvoj"
Profesor Vang ne osporava da se sada tehnologija nalazi u vrlo ranoj fazi razvoja.
U idealnom slučaju potrebno je da se nekako automatizuje i povratni proces, da se omogući da ćelija, ne samo da može da kopira i sačuva informaciju, već i da je samostalno negde prenese.
Tek onda će ona da nauči da u potpunosti „razgovara sa kompjuterom", a ne samo da sluša, već i odgovara.
Međutim, kako kaže programer to je još na dugačkom štapu.
Priroda je izumela mnogo načina koji omogućavaju stvaranje i promenu genetskog koda, a naučnici su tek počeli da ih savladavaju.

Autor fotografije, Columbia University
„Mi nismo bogovi", osmehuje se profesor.
„Mi samo koristimo DNK za učitavanje informacija. Mi smo pre umetnici ili pisci, ili programeri, koji stvaraju genetske programe sa nekakvim novim korisnim funkcionalnostima iz već gotovih elemenata."
Prema njegovim rečima, sledeći korak je da se pojednostavi prenos informacija iz kompjutera u ćeliju.
Sada se u te svrhe koristi protok elektrona ali u budućnosti može da bude zamenjen nečim drugim.
Na primer, naizmeničnim magnetnim poljem ili temperaturom spoljne sredine.
Ili čak običnim svetlosnim zrakom, pošto većina živih organizama ima fotoreceptore.
Tada će, sanja profesor, biti moguće da se mnogo brže kopiraju informacije na DNK, uostalom, biće moguće da se istovremeno snimi odmah na nekoliko frekvencija odjednom.
Međutim, Dmitrij Kolpaščikov gaji sumnje u to koliko će takav prenos podataka biti pouzdan.
Prema njegovim rečima, slične tehnologije (kada se iz jednog izvora odvija paralelno snimanje na talasima različitih dužina) već se koriste u medicinskoj dijagnostici.
On smatra da ovo nije pravac koji najviše obećava.
„Zašto se u kompjuterskim kodovima koristi binarni sistem - nule i jedinice? Jer je ovo najpouzdaniji zapis", smatra stručnjak.
Ako pređemo na drugi nivo, onda greške počinju da se nagomilavaju.
Upravo zbog toga veoma je teško izbeći binarni sistem u stvarnim uređajima, rizik od greške je preveliki.
„Generalno gledajući, skladištenje podataka nije glavni pravac za [tehnologiju kompjuterizovane] DNK", rezimira on.
„To je zaista korak u stranu. Koliko će biti uspešno, nije poznato ali ovaj razvoj je svakako zanimljiv i neobičan."

Pratite nas na Fejsbuku i Tviteru. Ako imate predlog teme za nas, javite se na [email protected]































